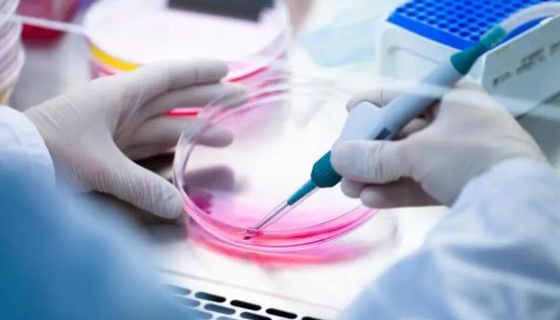
细菌溶血现象的检测方法与质量控制要点及应用价值！
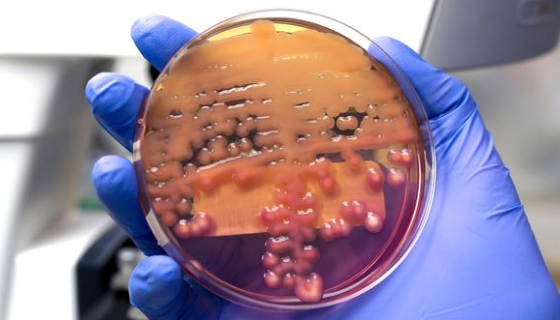
酵母浸出粉胨葡萄糖琼脂培养基的原理与应用及质控方法！

细菌溶血现象的检测方法与质量控制要点及应用价值!
细菌的溶血现象是指某些细菌在血琼脂培养基上生长时,通过分泌特...

NAC 琼脂培养基的标准化操作流程及核心注意事项!
NAC 琼脂培养基是一种选择性培养基,主要通过添加制霉菌素、...

解肝磷脂土地杆菌的培养保藏与应用价值及安全与质控!
解肝磷脂土地杆菌是土地杆菌属的模式菌株,革兰氏阴性、无芽孢短...

小鼠肝动脉平滑肌细胞分离与培养的标准化操作流程!
小鼠肝动脉平滑肌细胞是构成小鼠肝动脉血管壁的重要细胞类型之一...
酵母浸出粉胨葡萄糖琼脂培养基的原理与应用及质控方法!
酵母浸出粉胨葡萄糖琼脂培养基,简称 YPD 培养基,是微生物...

大鼠胸大动脉平滑肌细胞的分离培养方法及质量控制要点!
大鼠胸大动脉平滑肌细胞的分离培养以原代分离为主,常用组织贴块...

志贺氏菌生化与血清学鉴定方法的操作要点及注意事项!
志贺氏菌的鉴定需结合生化鉴定和血清学鉴定两步,生化鉴定用于筛...

淡紫色拟青霉的应用领域及其在有机农业中的应用前景!
淡紫拟青霉是有机农业线虫治理与土壤健康管理的核心生物资源,前...

血液增菌培养基使用过程中保证操作无菌性的具体实施方法!
在血液增菌培养基的使用中,无菌性是避免杂菌污染、确保低浓度致...